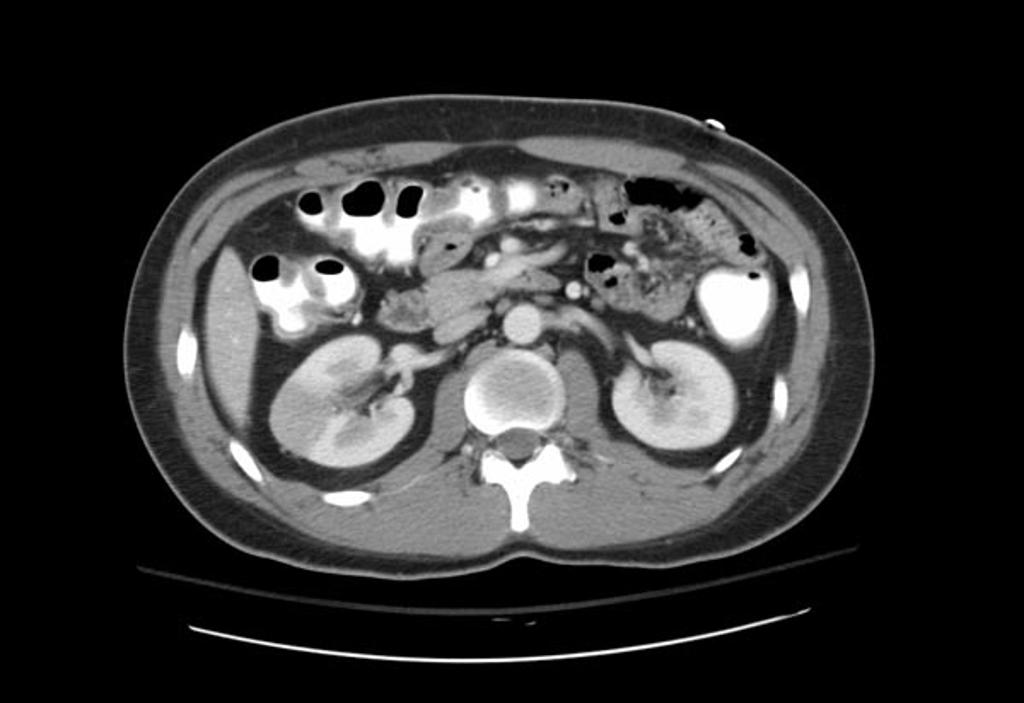

Author: Brit Long, MD (EM Resident Physician at SAUSHEC; USAF) // Editor: Alex Koyfman, MD (@EMHighAK)
It’s a slow night in the ED, and just as you take a sip of coffee to help wake you up, a 63 year-old male comes in from triage with right flank pain and nausea for two days. He has a history of coronary artery disease, diabetes, hypertension, and atrial fibrillation, but no prior kidney stones. His initial vital signs show HR 82, BP 155/92, RR 22, Sat 98% on room air, and temperature 98F. He denies fevers, PO intolerance, dysuria, abdominal pain, chest pain, or any other symptoms. Exam reveals no CVA tenderness or abdominal tenderness. However, his heart rhythm is irregularly irregular. You have seen this type of patient multiple times before, and you have your differential before you walk into the room.
Labs reveal RBCs in the urine with no WBCs, Cr of 1.4, GFR 62, and normal CBC and lactate. You wheel in your trusty US to the bedside, which reveals normal aorta, normal kidneys with no hydronephrosis, and a normal bladder. CT without contrast of the abdomen/pelvis returns normal, with no stone surprisingly. You were initially sure this patient had a stone or AAA. What could you be missing?
You order a CT abdomen/pelvis with IV contrast after discussing the patient with your radiologist, and the result is surprising: a right-sided renal infarction with extensive thrombus in the right renal artery! With these results, you immediately call your surgeon and interventional radiologist.
Background
Renal infarction is a rarely found clinical diagnosis. One study conducted in an ED showed an incidence of 0.007%!1 However, this is likely an underestimation. The incidence of this entity is probably higher due to the similar presentation to other diagnoses such as nephrolithiasis or pyelonephritis.1,2
There are several primary causes: 1) thromboemboli from the heart or aorta, 2) renal vessel injury (traumatic vs. iatrogenic), and 3) in-situ-thrombosis.1,2 The largest study of renal infarction includes 94 patients, and 25% (23 patients) presented due to emboli. Seventeen patients suffered from atrial fibrillation, 16% were due to renal artery thrombosis, and 31% presented due to vascular injury. However, no cause was found in 29% of patients!1
From this study, the two largest contributors are atrial fibrillation and vascular injury. In a study of 30,000 patients with atrial fibrillation, almost 2% of patients were found to have renal infarction over a 13 year period.
Presentation
Patients with large infarctions usually present with flank and/or abdominal pain (97% of the time), nausea (28%), vomiting (20%), and fever in 20%. However, small infarcts may be asymptomatic and found incidentally. Close to half of the time, patients will have an elevation in blood pressure, presumed to be due to increased renin release.1-5
Diagnosis
The key tests to order are CBC, renal function panel, LDH, ECG, and urine.3
Hematuria is present in close to half of patients, and it is usually microscopic. Proteinuria is uncommon. If the obstruction is unilateral, there may be no change in creatinine (Cr) and/or GFR! However, in patients with limited reserve, increased vascular disease, or bilateral infarction, Cr and GFR will worsen. LDH is elevated in 91% of these patients, with a mean level of 680! LFTs are usually normal.1 A key point is in patients with elevated LDH and normal liver enzymes, consider renal infarction!
As these patients will often present with a classic history for AAA and AAA risk factors, performing a quick bedside US is crucial. If the US is negative, often the next step would be CT with no contrast. If both CT and US are negative, then order CT with IV contrast, as long as the patient’s GFR is above 60 (though this is controversial and will not be covered; see past www.emdocs.net post on this topic). The classic finding on CT with IV contrast is a wedge-shaped perfusion defect.4 Other options include radioisotope scan, which is not often feasible with today’s imaging, and MRI, but this requires gadolinium enhancement which is associated with nephrogenic systemic fibrosis in patients with decreased renal function. Ultrasound of the kidneys and renal vessels unfortunately does not have the necessary sensitivity to rule out the diagnosis.
Treatment
Optimal treatment for renal infarction ultimately depends on the cause. Unfortunately there are no definitive studies that compare various treatment options. Three treatment plans are anticoagulation, endovascular treatment, and open surgery.
These patients must be discussed with your surgeon and interventional radiologist. With complete occlusion of the renal artery, revascularization can be difficult. However, if the patient has significant renal disease on the brink of renal failure or a solitary kidney, endovascular treatment can be renal-saving. Surgery is usually reserved for patients who suffer a trauma-related renal artery dissection, with resulting renal infarction.
Treatment should involve anticoagulation if the disease is due to embolus or thrombus, starting with heparin and then followed with warfarin. Anticoagulation is not warranted in renal artery dissection. If patients have involvement of the main renal artery or a segmental branch with infarction less than 2 days old, then percutaneous endovascular therapy is usually done. When the patient is hypertensive, normalization of blood pressure should be the goal, with first line agents including ACE inhibitors or angiotensin receptor blockers, as the primary cause of the hypertension is due to increased renin.1-10
Ultimately, the most effective treatment is percutaneous endovascular therapy.
In summary, look for the red flags of embolism (atrial fibrillation, CAD, poor ejection fraction, etc.). If non-contrast CT is negative, consider CT with IV contrast. LDH elevation can be helpful, and the best treatment is percutaneous endovascular therapy.
References / Further Reading:
- Bourgault M, Grimbert P, Verret C, et al. Acute renal infarction: a case series. Clin J Am Soc Nephrol 2013; 8:392.
- Paris B, Bobire G, Rossignol P, et al. Blood pressure and renal outcomes in patients with kidney infarction and hypertension. J Hypertens 2006; 24:1649.
- Domanovits H. Paulis M, Nikfardjam M, et al. Acute renal infarction. Clinical characteristics of 17 patients. Medicine (Baltimore) 1999; 78:386.
- Chu PL, Wei YF, Huang JW, et al. Clinical characteristics of patients with segmental renal infarction. Nephrology (Carlton) 2006; 11:336.
- Lumerman JH, Hom D. Eiley D, Smith AD. Heightened suspicion and rapid evaluation with CT for early diagnosis of partial renal infarction. J Endourol 1999; 13:209.
- Korzets, X, Plotkin E, Bernheim J, Zissin R. The clinical spectrum of acute renal infarction. Isr Med Assoc J 2002; 4:781.
- Tsai SH, Chu SJ, Chen SJ, et al. Acute renal infarction: a 10-year experience. Int J Clin Pract 2007; 61:62.
- London IL Hoffsten P, Perkoff GT, Pennington TG. Renal infarction. Elevation of serum and urinary lactic dehydrogenase (LDH). Arch Intern Med 1968; 121:87.
- Nakayama T, Okaneya T, Kinebuchi Y, et al. Thrombolytic therapy for traumatic unilateral renal artery thrombosis. Int J Urol 2006; 13:168.
- Cheng BC, Ko SF, Chuang FR, et al. Successful management of acute renal artery thromboembolism by intra-arterial thrombolytic therapy with recombinant tissue plasminogen activator. Ren Fail 2003; 25:665.
- http://www.ncbi.nlm.nih.gov/pubmed/22691187
- http://www.ncbi.nlm.nih.gov/pubmed/1443852
2 thoughts on “Renal Infarction: Pearls and Pitfalls”
Огромное Спасибо!
Pingback: emDOCs.net – Emergency Medicine EducationRenal colic mimics: Differential diagnosis and approach to management - emDOCs.net - Emergency Medicine Education